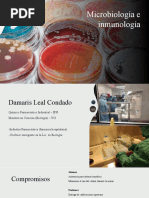

100% encontró este documento útil (1 voto)
93 vistas60 páginasProtocolo de RCP y Manejo de Paro Cardíaco
El documento describe las responsabilidades del equipo de respuesta a una emergencia de paro cardíaco, incluyendo al médico, enfermero A, enfermero B, enfermero C, enfermero D y supervisor. Explica los procedimientos de RCP, intubación, acceso vascular, medicamentos y el manejo general de un evento de paro cardíaco.
Cargado por
Luis GonzalezDerechos de autor
© © All Rights Reserved
Nos tomamos en serio los derechos de los contenidos. Si sospechas que se trata de tu contenido, reclámalo aquí.
Formatos disponibles
Descarga como PDF, TXT o lee en línea desde Scribd
100% encontró este documento útil (1 voto)
93 vistas60 páginasProtocolo de RCP y Manejo de Paro Cardíaco
El documento describe las responsabilidades del equipo de respuesta a una emergencia de paro cardíaco, incluyendo al médico, enfermero A, enfermero B, enfermero C, enfermero D y supervisor. Explica los procedimientos de RCP, intubación, acceso vascular, medicamentos y el manejo general de un evento de paro cardíaco.
Cargado por
Luis GonzalezDerechos de autor
© © All Rights Reserved
Nos tomamos en serio los derechos de los contenidos. Si sospechas que se trata de tu contenido, reclámalo aquí.
Formatos disponibles
Descarga como PDF, TXT o lee en línea desde Scribd